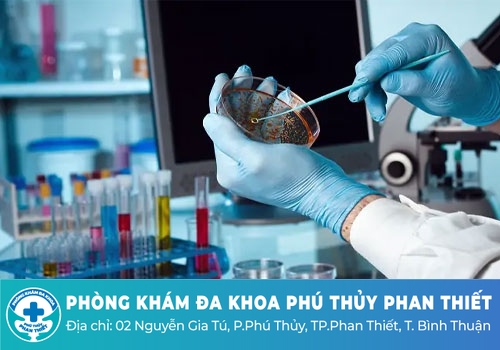

Công ty TNHH MTV dịch vụ y tế Phú Thủy Phan Thiết
02 Nguyễn Gia Tú, Khu phố 14, Thành phố Phan Thiết, Bình Thuận
Liên lạc: 0252 7303 888
Bệnh hạ cam là một trong những căn bệnh gây ra rất nhiều khó chịu cho người bệnh vì những vết lở loét dễ lây lan. Căn bệnh này có những triệu chứng cấp tính và cần được điều trị sớm nếu không nó sẽ có nguy cơ phá hủy cơ quan sinh dục. Nhiều bệnh nhân đến nay vẫn thắc mắc bệnh hạ cam có tự khỏi không? Để trả lời cho những thắc mắc này bạn hãy tham khảo bài chia sẻ bên dưới đây của các chuyên gia tại Phòng Khám Đa Khoa Phú Thủy Phan Thiết nhé.
Hạ cam được biết đến là một căn bệnh lây nhiễm thông qua đường tình dục là chủ yếu, với các biểu hiện làm vết loét tại cơ quan sinh dục, kèm theo triệu chứng viêm hạch bẹt mủ. Căn bệnh này lây lan nhanh chóng và cũng có thể điều trị tiến triển tốt chỉ sau một tuần.
Bệnh hạ cam xuất phát từ một lọ trực khuẩn gram âm, và có một tỷ lệ nhất định của người mắc bệnh hạ cam đi kèm với các bệnh xã hội khác như giang mai, herpes sinh dục,... Vậy nên để phát hiện được hạ cam một cách chính xác, bệnh nhân cần đi xét nghiệm để chẩn đoán và đồng thời điều trị kịp thời.
Những đối tượng có đời sống tình dục không lành mạnh sẽ có nguy cơ mắc hạ cam cũng như các bệnh truyền nhiễm khác qua đường tình dục. Một số yếu tố khiến gia tăng nguy cơ mắc bệnh hạ cam đó là:

⇒ Quan hệ tình dục không lành mạnh với gái mại dâm
⇒ Sử dụng các thức uống có cồn như bia rượu
⇒ Thực hiện quan hệ tình dục tập thể
⇒ Không chung thủy, có nhiều bạn tình
Mỗi người sẽ xuất hiện các triệu chứng bệnh hạ cam khác nhau, nhưng thông thường sau khi nhiễm bệnh từ 4 đến 7 ngày bệnh nhân sẽ xuất hiện các triệu chứng cụ thể như sau:
Nam giới có thể nhận thấy vết sưng nhỏ có màu đỏ tại cơ quan sinh dục. Vết sưng này có thể nhanh chóng trở thành vết loét hở, gây ra đau đớn tại cơ quan sinh dục của nam giới.
Ở nữ giới hạ cam xuất hiện với những vết mụn đỏ trên môi âm hộ, ở giữa môi âm hộ, hậu môn hoặc ở trên đùi. Các nốt mụn đỏ này sẽ nhanh chóng vỡ ra gây viêm loét và phụ nữ sẽ cảm thấy nóng rát khi đi vệ sinh.

Bên cạnh những triệu chứng khác biệt ở giữa nam và nữ giới thì cả hai cũng có những dấu hiệu bệnh hạ cam chung như:
♦ Các vết loét có thể khác nhau về kích thước và mức độ trung bình khoảng từ 1 đến 2 cm.
♦ Trong một số trường hợp người bệnh có thể xuất hiện các vết loét với kích thước lớn hơn.
♦ Các vết loét thường có đầu xám hoặc vàng xám với bờ nham nhở.
♦ Thường khi chạm vào các vết loét rất dễ chảy máu.
Ngoài ra bất kỳ ai khi bị mắc bệnh hạ cam đều có nguy cơ đối diện với các triệu chứng như:
♦ Đau đớn thì đi tiểu tiện hoặc quan hệ tình dục
♦ Sưng hạch bạch huyết ở bẹn
♦ Hạch bạch huyết sưng to, chúng có thể vỡ ra xuyên qua lớp da dẫn đến tình trạng áp xe hoặc tụ mủ.
Nhiều bệnh nhân thắc mắc bệnh hạ cam có tự khỏi không? Theo các chuyên gia y tế một số trường hợp người bệnh có thể tự khỏi sau 1 đến 2 tháng mặc dù không chủ động điều trị. Tuy nhiên nếu để hạ cam tự khỏi người bệnh có thể đối diện với việc hình thành sẹo tại cơ quan sinh dục. Ngoài ra không phải trường hợp nào bệnh hạ cam cũng có thể tự khỏi, đa số bệnh sẽ diễn biến nặng hơn và bệnh nhân phải đối diện với rất nhiều biến chứng nguy hiểm.
Người bệnh có nguy cơ cao dễ bị viêm hạch bạch huyết cũng như nhiễm trùng mô mềm. Căn bệnh của người ảnh hưởng đến chất lượng cuộc sống và đời sống tình dục của người bệnh. Mắc phải hạ cam thì nguy cơ mắc thêm các bệnh xã hội khác là cao hơn, đặc biệt là bệnh HIV.

Bệnh hạ cam hoàn toàn có thể điều trị bằng thuốc hoặc tác dụng các phương pháp phẫu thuật để khắc phục được các biến chứng. Dưới đây là một số phương pháp để điều trị cho tình trạng hạ cam:
Các bác sĩ có thể điều trị hạ cam bằng sử dụng thuốc kê đơn cho bệnh nhân. Thuốc được sử dụng là thuốc kháng sinh có khả năng tiêu diệt vi khuẩn, ngăn ngừa nguy cơ để lại sẹo sau khi các vết loét lành.
Các bác sĩ sẽ sử dụng thuốc kháng sinh phù hợp với liều lượng cụ thể tùy theo tình trạng của bệnh nhân. Điều quan trọng là bệnh nhân phải tuân theo chỉ định và bác sĩ đưa ra, không được ngưng thuốc giữa chừng, ngay cả khi nhận thấy các vết loét đã có dấu hiệu lành lại.
Trong tình trạng hạch bạch huyết có lớn gây ra nhiều đau đớn cho bệnh nhân thì các bác sĩ sẽ chỉ định thực hiện dẫn lưu áp xe bằng việc sử dụng kim thông hoặc phẫu thuật. Áp dụng phương pháp này sẽ giúp giảm đi tình trạng sưng đau ở các vết loét, ít gây ra sẹo sau tổn thương.
Và bệnh nhân lưu ý phải lựa chọn được cơ sở uy tín và chất lượng để chữa trị cho tình trạng bệnh hạ cam. Một trong những địa chỉ uy tín và an toàn bệnh nhân có thể tin tưởng đó là Phòng Khám Đa Khoa Phú Thủy Phan Thiết nằm ở 2 Nguyễn Gia Tú, Phú Thuỷ, Thành phố Phan Thiết, Bình Thuận . Khi bệnh nhân đến đây thăm khám và chữa trị bệnh có thể tin tưởng vào chất lượng về:
► Phòng khám nổi tiếng với các bác sĩ là chuyên gia hàng đầu về lĩnh vực bệnh xã hội.
► Quy trình thăm khám ở bệnh viện nhanh chóng, được nhân viên y tế hỗ trợ hướng dẫn chi tiết.
► Các phương pháp thăm khám và chữa trị các bệnh như hạ cam đều áp dụng công nghệ với máy móc hiện tại và khoa học.
► Phòng khám cũng cho xây dựng phòng thuốc riêng giúp bệnh nhân có thể thoải mái điều trị và yên tâm về chất lượng.
► Không gian phòng khám bệnh cũng như điều trị riêng tư, giúp cho bệnh nhân có tâm lý thoải mái và yên tâm hơn khi điều trị.
► Toàn bộ chi phí chữa trị tình trạng hạ cam cũng như các bệnh xã hội khác đều nằm ở mức phù hợp, được công khai cụ thể trước khi thực hiện điều trị.
Những thông tin mà chúng tôi chia sẻ trên đây chắc hẳn đã giải đáp được thắc mắc bệnh hạ cam có tự khỏi không? Nếu thấy xuất hiện các dấu hiệu của bệnh đường chủ quan mà hãy lựa chọn việc tham khảo để điều trị càng sớm càng tốt. Khi chưa thể đi thăm khám trực tiếp bệnh nhân có thể gọi điện đến hotline 0252 7303 888 hoặc click vào khung chat bên dưới đây nhé. Phòng khám sẽ có đội ngũ tư vấn viên hoạt động 24/7 sẵn sàng tiếp nhận vấn đề và hỗ trợ cho bệnh nhân.
Phòng Khám Đa Khoa Phú Thủy Phan Thiết địa chỉ: 2 Nguyễn Gia Tú, Phú Thuỷ, Thành phố Phan Thiết, Bình Thuận
- Đặt lịch hẹn qua số điện thoại: 0252 7303 888 để được đăng ký khám sớm không mất công chờ đợi.
- Đăng ký ngay để nhận tư vấn và dịch vụ ưu đãi: